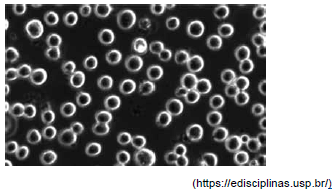
Enunciado 3161487-1

Foram encontradas 50 questões.
Um técnico, ao realizar a contagem de células de sua cultura celular na câmara de Neubauer, conforme procedimento padrão obteve as seguintes quantidades: 5; 6; 5; 4. Considerando que a suspensão celular foi previamente diluida 1:1, o número de células por mL, dessa suspensão celular, é
Provas
A imagem a seguir foi obtida na observação ao microscópio óptico de uma cultura celular da linhagem K562 (eritroleucemia).
Sobre as células dessa linhagem celular, é correto afirmar que são
Provas
Para o cultivo de linhagens celulares são utilizados meios nutritivos que fornecem as substâncias essenciais para o crescimento celular, como sais minerais, açúcares, aminoácidos, lipídeos e vitaminas. Nesses meios de cultura também costuma-se adicionar fluidos animais, como o soro. Há, no entanto, meios de cultura mais complexos, livres de fluidos animais, sendo essencial, nesse caso, a adição de
Provas
As culturas de linhagens celulares, especialmente de mamíferos, constituem uma ferramenta fundamental nas pesquisas biológicas. Uma das aplicações em Biotecnologia é a produção de anticorpos monoclonais, utilizados em inúmeros imunoensaios disponíveis atualmente. Para isso, são realizadas culturas de células denominadas hibridoma, resultantes de
Provas
A contaminação cruzada de uma cultura de células é um problema sério, pois pode comprometer os resultado do estudo. Estima-se que 15% a 20% das linhagens celulares atualmente em uso apresentam esse tipo de contaminação. Esse tipo de contaminação é causado
Provas
Ao cultivar qualquer tipo de célula em um ambiente de laboratório, evitar a contaminação é sempre a preocupação principal. Alguns contaminantes são fáceis de serem detectados, enquanto outros são mais difíceis, mas ainda podem ser monitorados por meio de kits de teste disponíveis no mercado. Um desses testes é o de lisado de amebócito Limulus (LAL), derivado do sangue de caranguejos- ferradura. Ao ser utilizado, uma enzima desse testes inicia uma cascata de coagulação, que pode ser usada para
Provas
O glicerol é utilizado em processos criogênicos devido ao fato de ser um crioprotetor por sua capacidade de
Provas
A criopreservação é um procedimento que permite armazenar células por longos períodos. Mas, para isso, o material biológico precisa receber o tratamento e preparação adequados, pois, durante esse processo, a formação de cristais devido ao congelamento da água e a reorganização no interior da célula leva ao rompimento da membrana plasmática, resultando em morte celular. Além de outros cuidados necessários, esse efeito indesejado é impedido por meio
Provas
Um espectrofotômetro é totalmente programável, isto é, ele realizará a leitura de acordo com o comprimento de onda estabelecido pelo usuário. Caso ele necessite utilizar o espectrofotômetro na faixa do visível, essa faixa está, em nm, compreendida entre
Provas
O espectrofotômetro é instrumento utilizado em análises colorimétricas. Esta técnica visa determinar a concentração de uma substância pela medida da absorção relativa de luz, tomando como referência a absorção da substância numa concentração conhecida. A ilustração a seguir representa de forma simplificada o funcionamento de espectofotômetro de feixe simples.

Na ilustração, a solução problema e a seleção do comprimento de onda a ser usado na amostra estão representadas, respectivamente, por:
Provas
Caderno Container